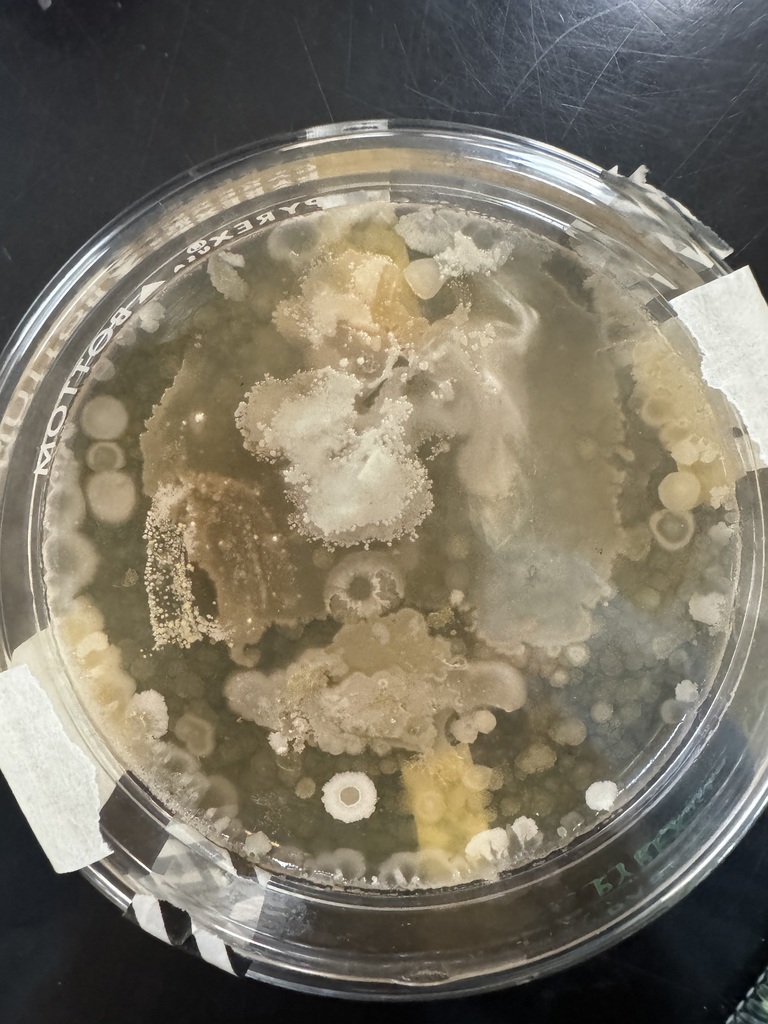
x

Dance Team Tryout Information!
Tryout Registration Form:
https://docs.google.com/forms/d/e/1FAIpQLSeMN6NpyUOMZhMqoWxgviTcI5dZGlP6OWmxML58brAMzOWGSA/viewform
Tryout Registration Form:
https://docs.google.com/forms/d/e/1FAIpQLSeMN6NpyUOMZhMqoWxgviTcI5dZGlP6OWmxML58brAMzOWGSA/viewform

For current 8th - 11th graders:
🚨 2026 FOOTBALL PARENT MEETING 🚨
We’d love for all parents of current 8th graders through current juniors who are planning to play this upcoming season to join us!
This meeting is a great opportunity to meet the coaching staff who will be investing in your son, hear important details about our summer and season schedule, discuss our program values, and get answers to any questions you may have.
📍 LHS Auditorium
🗓️ Sunday, April 26
⏰ 4:30 PM
We’re excited about the season ahead and look forward to partnering with you as we invest in and help shape these young men into who we know they can be!
For more information, contact Coach Carr at Carr.derek@hcschoolstn.org
GBR

📣 Free Sports Physicals for 2026–2027
Take advantage of FREE sports physicals on May 11th at LHS, courtesy of Henderson County Medical Group!
Physical packets will be distributed by coaches on or after April 15th. Please review the packet with your athlete, complete the health history, and sign all required sections.
Once the packet is complete, stop by Ms. Erin’s office to finish the pre-screening (vision, height, weight, etc.) before May 11th. Completing this step ahead of time will help everything run smoothly on physical day.
If you choose not to participate, you may use the same packet with your personal doctor. Please return a completed copy to your athlete’s coach.
Take advantage of FREE sports physicals on May 11th at LHS, courtesy of Henderson County Medical Group!
Physical packets will be distributed by coaches on or after April 15th. Please review the packet with your athlete, complete the health history, and sign all required sections.
Once the packet is complete, stop by Ms. Erin’s office to finish the pre-screening (vision, height, weight, etc.) before May 11th. Completing this step ahead of time will help everything run smoothly on physical day.
If you choose not to participate, you may use the same packet with your personal doctor. Please return a completed copy to your athlete’s coach.

Mrs. Walker’s Spanish II classes recently completed their “La Casa” project! Students used their vocabulary knowledge to create a foldable house featuring six different rooms. They had a great time working on the project, and Mrs. Walker is proud of their creativity and effort.



Press Release – Lexington High School Announces Resignation of Head Girls Basketball Coach
Lexington High School announces the resignation of Head Girls Basketball Coach Shelby Bowman after seven seasons leading the Lady Tigers. We are grateful for her dedication and the impact she has made on our student-athletes. We wish Coach Bowman the very best in her future endeavors.
Lexington High School will begin the search for its next head girls basketball coach immediately.
Lexington High School announces the resignation of Head Girls Basketball Coach Shelby Bowman after seven seasons leading the Lady Tigers. We are grateful for her dedication and the impact she has made on our student-athletes. We wish Coach Bowman the very best in her future endeavors.
Lexington High School will begin the search for its next head girls basketball coach immediately.
We are so proud to celebrate our assistant principals at Lexington High School! Thank you for all you do each day for our students, staff, and school. Your leadership, dedication, and care make a difference every single day. We appreciate you!



LHS Announcements for April 7-10
https://docs.google.com/document/d/1_PTZxio4T-aofbiWBgfbRg3FYu_qWlgTka0XPafvTtY/edit?usp=sharing
https://docs.google.com/document/d/1_PTZxio4T-aofbiWBgfbRg3FYu_qWlgTka0XPafvTtY/edit?usp=sharing

FCA starts back up tomorrow! Martha Ann Evans will be speaking at 7:20 in Coach Fitch's Room. Be sure to check out the website for the speaker schedule each week.

ATTENTION SENIORS:
Prom ticket sales have been extended for one more day. If you have not already, you can purchase a ticket from Mrs. Rainey in room 143 on Tuesday, 4/7. This is the absolute last day. Please share this with your classmates so that everyone is aware of the extended ticket deadline. All seniors just received an email about tickets, decorating, and other info. Please read it and let Mrs. Rainey know if you have any questions.
Prom ticket sales have been extended for one more day. If you have not already, you can purchase a ticket from Mrs. Rainey in room 143 on Tuesday, 4/7. This is the absolute last day. Please share this with your classmates so that everyone is aware of the extended ticket deadline. All seniors just received an email about tickets, decorating, and other info. Please read it and let Mrs. Rainey know if you have any questions.

🌸 Spring Break is Here! 🌸
Henderson County Schools will be on spring break from Monday, March 30, through Friday, April 3. We hope our students, staff, and families enjoy a well-deserved week of rest, fun, and rejuvenation!
Staff development will take place on Monday, April 6, and students will return to class on Tuesday, April 7.
Enjoy your break, stay safe, and we look forward to seeing everyone back and ready for a strong finish to the school year!
#HCSchools #SpringBreak
Henderson County Schools will be on spring break from Monday, March 30, through Friday, April 3. We hope our students, staff, and families enjoy a well-deserved week of rest, fun, and rejuvenation!
Staff development will take place on Monday, April 6, and students will return to class on Tuesday, April 7.
Enjoy your break, stay safe, and we look forward to seeing everyone back and ready for a strong finish to the school year!
#HCSchools #SpringBreak

The Match with Hardin County today has been canceled and unfortunately will not be rescheduled.

LHS Announcements for March 23-27
https://docs.google.com/document/d/1_PTZxio4T-aofbiWBgfbRg3FYu_qWlgTka0XPafvTtY/edit?usp=sharing
https://docs.google.com/document/d/1_PTZxio4T-aofbiWBgfbRg3FYu_qWlgTka0XPafvTtY/edit?usp=sharing

Coach Mac's Chemistry 2 class experimented with aspirin titrations this morning.







Mrs. Beatty's biology class went on a microbial scavenger hunt. Where do you think the most germs are on campus?

Today's and tomorrow's tennis matches have been cancelled. We will share updated information when the matches have been rescheduled.

LHS Announcements for March 16-20
https://docs.google.com/document/d/1_PTZxio4T-aofbiWBgfbRg3FYu_qWlgTka0XPafvTtY/edit?usp=sharing
https://docs.google.com/document/d/1_PTZxio4T-aofbiWBgfbRg3FYu_qWlgTka0XPafvTtY/edit?usp=sharing

Students in Coach Ryne Bivens’ Business Communication class at Lexington High School recently participated in a Shark Tank–style project where they designed, marketed, and pitched their own business ideas to a panel of teachers and administrators.
2026 Bass Master Classic High School Champions 🏆

The Lexington High School Concert Band participated in the WTSBOA Concert Performance Assessment on Thursday, March 12 at UT Martin. The band received scores of 2 (Excellent) from all three judges of prepared music and a score of 1 (Superior) in sightreading.
Congratulations on a great performance today!

Come support the Susan Walker Scholarship Foundation tonight at Great Pretenders. We will have an El Potrillo silent auction basket valued at over $150! Concessions will be sold. The doors open at 5:30 and the show begins at 6. We hope to see you there! 💃🪩🕺


